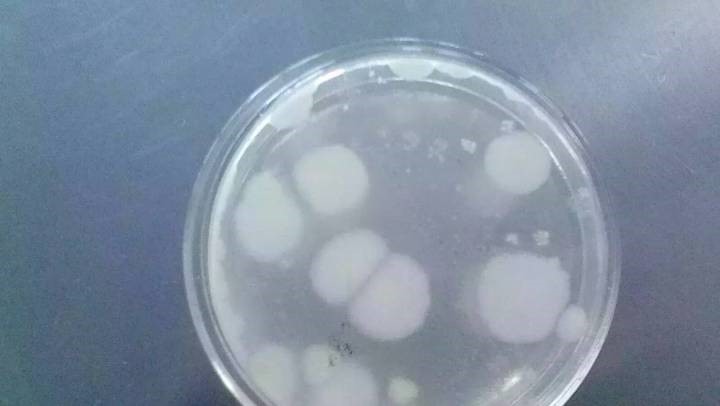

雙11來臨現(xiàn)在有很多商家問題層出不窮,這不剛不久就有一個(gè)菌落超標(biāo)近7倍假面膜泛濫的事情讓大家有點(diǎn)小郁悶,其實(shí)遇到這樣的事我們怎么選擇呢��?不要擔(dān)心且看武漢ISO認(rèn)證如何讓你放心�。

像這樣的事情��,面膜箘落超標(biāo)是什么概念�����,我來給大家解釋一下就是菌落總數(shù)沒達(dá)標(biāo)�����,而它反映食品在生產(chǎn)過程中是否符合衛(wèi)生要求���,以便對(duì)被檢樣品做出適當(dāng)?shù)男l(wèi)生學(xué)評(píng)價(jià)���。我想這會(huì)讓很多愛美的小公主們十分難受吧。
大家熟悉的美即面膜�、韓后面膜也是有點(diǎn)點(diǎn)的小問題的,美即�����、韓后等面膜含微量甲醛,皮膚敏感者慎用其菌落總數(shù)超標(biāo)6.6倍�����,大家看了之后心里可能會(huì)有這樣的反應(yīng)���。

其實(shí)出現(xiàn)這種箘落超標(biāo)的事無非就是因?yàn)椋a(chǎn)公司以及銷售商們不太注重以“顧客為關(guān)注焦點(diǎn)”沒有站在我們顧客角度著想����,而這一思想是是咱們ISO9001質(zhì)量管理體系認(rèn)證的思想。現(xiàn)在武漢其實(shí)有這樣的公司存在的他們引進(jìn)ISO9001的認(rèn)證體系�����,武漢ISO認(rèn)證還是出具小規(guī)模的����。
而這樣的本公司這是我們這些消費(fèi)者首選,如果你是位企業(yè)家�����,如果你還想雙11來臨之際讓消費(fèi)者放心,你可以選擇引進(jìn)質(zhì)量觀體系��,我相信引進(jìn)體系不僅只是你所必要做的事�,而是必然的事,現(xiàn)在人的對(duì)商家的信任在逐漸被人摧毀了�,引進(jìn)體系是必然的,選擇認(rèn)證咨詢公司又是一件比較困難的事�����,不要急�,歡迎咨詢武漢華美認(rèn)證咨詢有限公司。